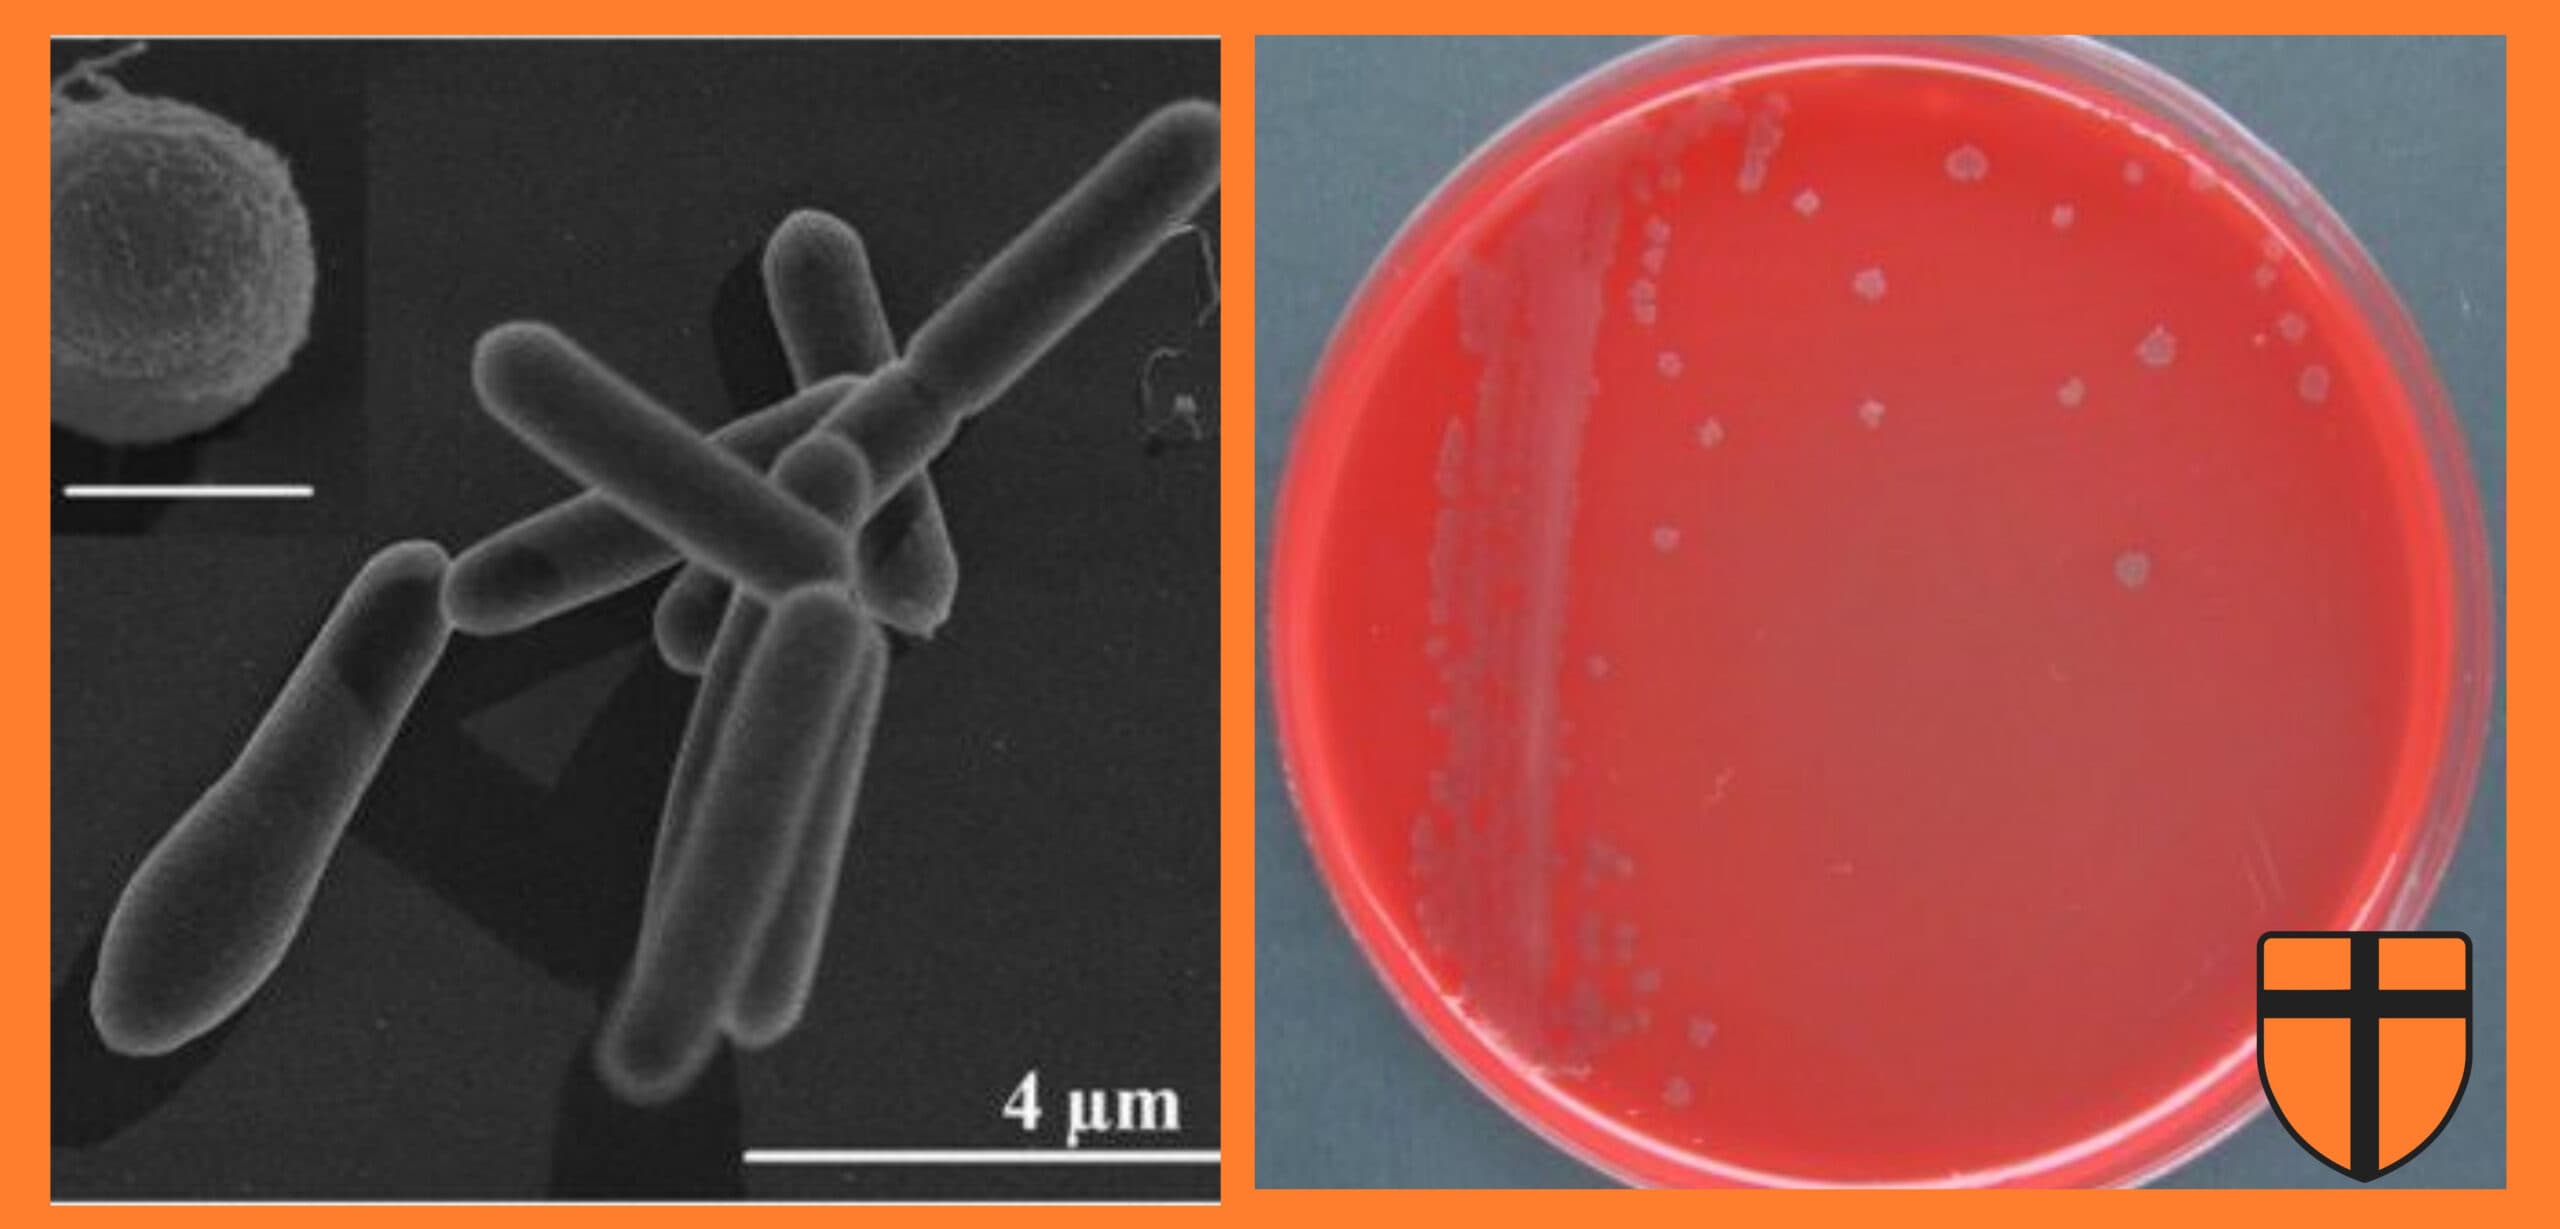

Putting AI at the Service of the Church: How a Catholic Chatbot could help Evangelization
At the recent forum held by the Pontifical Oriental Institute in Rome, CatholicTech faculty, including Fr. Michael Baggot and Fr. Philip Larrey, and board member Matthew Sanders, spoke on the potential benefits of AI in the work of the Church’s evangelization.
Fr. Baggot spoke at the forum on AI and the Catholic Church, and also talked with Justin McLellan from the USCCB on how the internet helped him during his conversion to the Church. Fr. Baggot said that while we must be aware of our human nature and sinfulness, we must also have confidence in our ability to use these technologies for good.
Matthew Sanders, a board member of CatholicTech and CEO of the digital service company Longbeard, also demonstrated a new large language model called MagisteriumAI. Similar to the inface of ChatGPT, MagisteriumAI has the potential to respond to those in need of Catholic guidance based on more than 5,700 magisterial documents and over 2,300 other Catholic theological and philosophical works. This can help people who are looking for answers while also being transparent about where the answers are coming from.

This new technology could getting benefit those looking to come back to the Church; while it may not be perfect, it can be a good tool to open the door for those who desire to start a conversation. Sanders and Fr. Baggot both mentioned that the use of these tools can help bring in-person experiences for people to engage in theological and philosophical conversation.
The Catholic News Service also interviewed Fr. Larrey on the Church’s response to AI. Listen to his response to the question of AI can be used promote the mission of the Gospel in the video above!